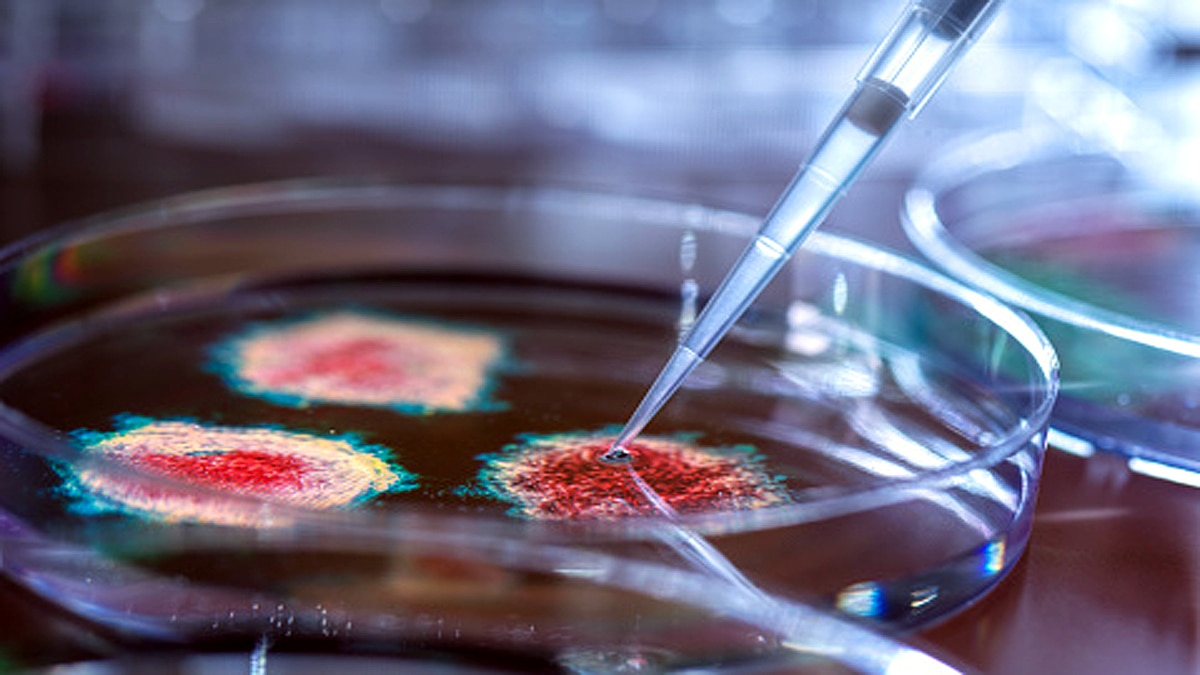
Vaccine Induced Antibodies less Effective against New Corona

4 बड़े संस्थानों का दावा- कितनी भी वैक्सीन लगा लो, नए कोरोना वायरस पर कम असर!
दुनिया के चार बड़े मेडिकल शोध संस्थानों ने दावा किया है कि वर्तमान में लग रही वैक्सीन नए कोरोना वायरस के कुछ वैरिएंट्स पर बेअसर हैं. या इनका असर कम होगा. ये संस्थान हैं- रैगन इंस्टीट्यूट ऑफ एमजीएच, एमआईटी, हार्वर्ड और मैस्याच्युसेट्स जनरल हॉस्पिटल. इनके वैज्ञानिकों का दावा है कि वर्तमान में लग रही कोरोना वैक्सीन से कुछ नए कोरोना वायरस पर कम असर होगा. (फोटोःगेटी)
ये नए कोरोना वायरस वैक्सीन से विकसित एंटीबॉडी और इंसान की प्रतिरोधक क्षमता को धोखा दे सकते हैं. जो नए कोरोना वायरस मिले हैं वो कैलिफोर्निया, डेनमार्क, यूके, दक्षिण अफ्रीका, ब्राजील और जापान में मिले हैं. यह स्टडी हाल ही में Cell में प्रकाशित हुई है. (फोटोःगेटी)
रैगन इंस्टीट्यूट के शोधकर्ता अलेजांड्रो बालास ने कहा कि फाइजर (Pfizer) और मॉडर्ना (Moderna) की कोविड-19 वैक्सीन ब्राजील, जापान और दक्षिण अफ्रीका में मिले कोरोना वायरस के नए स्ट्रेन पर कम असरदार है. अलेजांड्रो ने बताया कि हम HIV न्यूट्रीलाइजिंग एंटीबॉडीज का अध्ययन कर रहे थे. तभी कोरोना वायरस के नए स्ट्रेन्स के बारे में ख्याल आया. फिर हमने ये स्टडी की. (फोटोःगेटी)
अलेजांड्रो बालास हार्वर्ड मेडिकल स्कूल में मेडिसिन के प्रोफेसर भी हैं. उन्होंने बताया कि जब हमने इन नए कोरोना स्ट्रेन्स की जांच वैक्सीन इंड्यूस्ड एंटीबॉडी (वैक्सीन लगने के बाद विकसित हुई एंटीबॉडी) से कराई तो हैरतअंगेज और डरावने नतीजे सामने आए. दक्षिण अफ्रीका में मिला स्ट्रेन पुराने कोरोना वायरस की तुलना में वर्तमान वैक्सीनों से बचने में 20 से 40 गुना ज्यादा क्षमतावान है. (फोटोःगेटी)
वहीं, ब्राजील और जापान में मिले दो नए स्ट्रेन्स वर्तमान वैक्सीनों से बचने में 5 से 7 गुना ज्यादा क्षमतावान है. जबकि, 2019 में आया कोरोनावायरस कोविड-19 इन वैक्सीन से निष्क्रिय हो रहा है. यानी कि म्यूटेशन के बाद विकसित हुए नए कोरोना वायरस पर फिलहाल दी जा रही वैक्सीन का असर कम हो रहा है. यानी अगर इनसे संक्रमित शख्स को वैक्सीन दी भी जाए तो उसे ज्यादा लाभ नहीं होगा. (फोटोःगेटी)
अलेजांड्रो कहते हैं कि न्यूट्रीलाइजिंग एंटीबॉडीज (Neutrilizing Antibodies) वो होते हैं जो कोरोनावायरस के जोर से पकड़ लेते हैं और उन्हें शरीर की कोशिकाओं में घुसकर प्रजनन और संक्रमण करने का मौका नहीं देते. लेकिन ये तभी होता है जब एंटीबॉडी का आकार कोरोना वायरस के आकार के सामान हो. अगर वायरस का आकार बदल गया तो एंटीबॉडी कुछ नहीं कर पाएंगी. (फोटोःगेटी)
अगर कोरोनावायरस के स्पाइक प्रोटीन यानी बाहरी परत जिससे वह शरीर की कोशिकाओं से चिपकता है, उसका रूप बदल जाए तो एंटीबॉडी उसका कुछ नहीं कर सकती. तब वायरस न्यूट्रीलाइजेशन की प्रक्रिया से रेसिसटेंट हो जाता है यानी इस पर वैक्सीन, एंटीबॉ़डी या शारीरिक प्रतिरोधक क्षमता का कम असर होता है. (फोटोःगेटी)
इस स्टडी को करने वाले मुख्य शोधकर्ता और एमजीएच में डिपार्टमेंट ऑफ पैथोलॉजी के रेसिडेंट फिजिशियन डॉ. विलफ्रेडो गार्सिया-बेलट्रान ने कहा कि हमनें कोरोना वायरस के स्पाइक प्रोटीन के कुछ हिस्सों में म्यूटेशन देखा है. ये म्यूटेशन रिसेप्टर बाइंडिंग डोमेन में हुआ है. इसकी वजह से वायरस वैक्सीन, एंटीबॉडी और प्रतिरोधक क्षमता को धोखा दे पा रहे हैं. (फोटोःगेटी)
विलफ्रेडो ने बताया कि दक्षिण अफ्रीका में तीन वैरिएंट्स मिले हैं. तीनों वैक्सीन रेसिसटेंट हैं. इनके स्पाइक प्रोटीन के रिसेप्टर बाइंडिंग डोमेन में म्यूटेशन हुआ है. फिलहाल सभी कोरोना वैक्सीन शरीर को कोरोनावायरस के खिलाफ एंटीबॉडी बनाना सिखा रही हैं. ताकि कोरोना वायरस का स्पाइक प्रोटीन शरीर की कोशिकाओं से चिपक न सके. लेकिन ये नए कोरोना वायरस पर इन वैक्सीन्स का कम असर हो रहा है. (फोटोःगेटी)